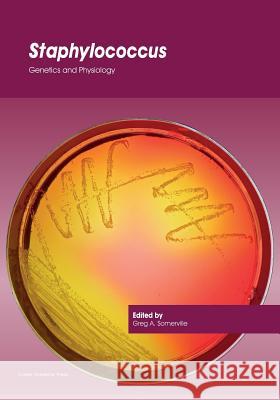
Staphylococcus: Genetics and Physiology Greg a. Somerville 9781910190494 Caister Academic Press - książka

Staphylococcus: Genetics and Physiology » książka
Staphylococcus: Genetics and Physiology
ISBN-13: 9781910190494 / Angielski / Miękka / 2016 / 400 str.
In the twenty first century, the bacterium Staphylococcus aureus continues to be a global threat to human and animal health. There is currently no vaccine for preventing S. aureus infections and the bacterium has developed resistance to many, if not most, antibiotics, hence the therapeutic options are rapidly disappearing. The genetic and physiological flexibility that allows this commensal bacterium to become a powerful pathogen and elucidating the myriad of mechanisms it employs to avoid the host and/or antimicrobials are important areas of research. This book brings together respected S. aureus experts from around the world to provide a timely overview of staphylococcal research. Topics covered include: medical significance; genetic variation; virulence factors; metabolism; proteomics; cell wall assembly; antibiotic resistance; genetic regulation; and immune response. Essential reading for scientists working with staphylococci. This text is an excellent introduction for entry level scientists, as well as those seeking a deeper understanding of this critically important bacterial pathogen.
In the twenty first century, the bacterium Staphylococcus aureus continues to be a global threat to human and animal health. There is currently no vaccine for preventing S. aureus infections and the bacterium has developed resistance to many, if not most, antibiotics, hence the therapeutic options are rapidly disappearing. The genetic and physiological flexibility that allows this commensal bacterium to become a powerful pathogen and elucidating the myriad of mechanisms it employs to avoid the host and/or antimicrobials are important areas of research.This book brings together respected S. aureus experts from around the world to provide a timely overview of staphylococcal research. Topics covered include: medical significance; genetic variation; virulence factors; metabolism; proteomics; cell wall assembly; antibiotic resistance; genetic regulation; and immune response.Essential reading for scientists working with staphylococci. This text is an excellent introduction for entry level scientists, as well as those seeking a deeper understanding of this critically important bacterial pathogen.